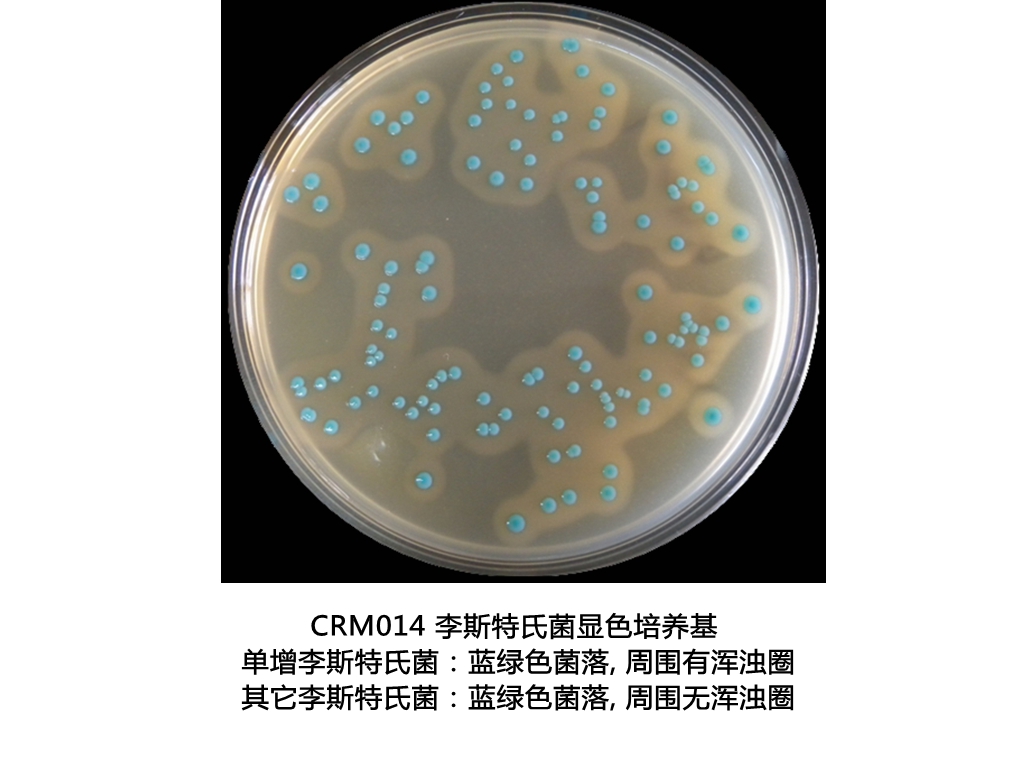
李斯特氏菌显色培养基平板生物图册

相关产品推荐更多 >
万千商家帮你免费找货
0 人在求购买到急需产品
- 详细信息
- 文献和实验
- 技术资料
- 库存:
9999
- 英文名:
Chromogenic Listeria Agar Plate
- 保质期:
3~6个月,实际以产品标签为准
- 供应商:
广东环凯
- 保存条件:
2-8℃,贮存于避光处
- 规格:
90mm×20个/盒
产品名称:李斯特氏菌显色培养基平板
英文名称:Chromogenic Listeria Agar Plate
其他叫法:李斯特氏菌显色平板 | 李斯特菌显色平板培养基
产品编号与包装规格:
| 产品编号 | 产品类型 | 包装规格 |
| CRM014P1 | 即用型成品平板 | 90mm×20个/盒 |


产品用途:用于分离和初步鉴别单增李斯特氏菌和其它李斯特菌。
使用方法:在洁净环境,打开包装即可使用,需注意无菌操作。
质量控制:(下列质控菌株接种后于35~37℃培养24±3h,观察结果如下表:)
| 指标 | 质控菌株及编号 | 标准值 | 特征性反应 |
| 生长率 | 单核细胞增生李斯特氏菌 ATCC19115 | PR≥0.5 | 蓝绿色光滑规则小菌落,周围有乳白色脂肪沉淀环 |
| 单核细胞增生李斯特氏菌 CMCC(B)54007 | |||
| 特异性 | 英诺克李斯特氏菌 ATCC33090 | —— | 蓝绿色光滑规则小菌落 |
| 选择性 | 大肠埃希氏菌 ATCC25922 | G≤1 | —— |
| 粪肠球菌 ATCC29212 | |||
| 白色念珠菌 ATCC10231 |
产品更多介绍详见 CRM014 李斯特氏菌显色培养基 干粉 1000mL
李斯特氏菌显色培养基平板 相关显色培养基产品目录 :
| 产品货号 | 产品名称 | 产品规格 | 产品用途 |
| CRM014 | 李斯特氏菌显色培养基 | 1000mL/瓶 | 用于分离和初步鉴别单增李斯特氏菌和其它李斯特菌 |
| CRM001 | 大肠菌群显色培养基 | 1000mL/瓶 | 24 小时平板法快速检测大肠菌群 |
| CRM001A | 大肠菌群显色培养基平板 | 90mm×20个/盒 | |
| CRM002 | 大肠杆菌显色培养基 | 1000mL/瓶 | 24 小时平板法快速检测大肠杆菌 |
| CRM002A | 大肠杆菌显色培养基平板 | 90mm×20个/盒 | |
| CRM003 | 大肠菌群大肠杆菌(ECC)显色培养基 | 1000mL/瓶 | 24 小时平板法快速检测大肠菌群大肠杆菌 |
| CRM003A | 大肠菌群大肠杆菌(ECC)显色培养基平板 | 90mm×20个/盒 | |
| CRM004 | 沙门氏菌显色培养基 | 1000mL/瓶 | 用于沙门氏菌的分离和初步鉴定 |
| CP0560 | 沙门氏菌显色培养基平板 | 90mm×20个/盒 | |
| CRM005 | 蜡样芽胞杆菌显色培养基 | 1000mL/瓶 | 用于蜡样芽孢杆菌的选择性分离和初步鉴别 |
| CRM005A | 蜡样芽孢杆菌显色培养基平板 | 90mm×20个/盒 | |
| CRM006 | 阪崎肠杆菌显色培养基(DFI琼脂) | 1000mL/瓶 | 主要用于婴儿奶粉以及其他食品中的阪崎肠杆菌的快速鉴定和计数 |
| CRM006B | 阪崎肠杆菌显色培养基(DFI琼脂)平板 | 90mm×20个/盒 | |
| CRM007 | 大肠杆菌O157:H7显色培养基 | 1000mL/瓶 | 用于大肠杆菌 O157:H7 的快速分离和鉴定 |
| CRM007B | 大肠杆菌O157:H7显色培养基平板 | 90mm×20个/盒 | |
| CRM008 | 弧菌显色培养基 | 1000mL/瓶 | 用于弧菌特别是副溶血性弧菌的分离和初步鉴定 |
| CP0570 | 弧菌显色培养基平板 | 90mm×20个/盒 | |
| CRM009 | 霍乱-弧菌显色培养基 | 1000mL/瓶 | 用于霍乱-弧菌的快速分离和初步鉴别 |
| CRM009B1 | 霍乱-弧菌显色培养基平板 | 90mm×20个/盒 | |
| CRM010 | 念珠菌显色培养基 | 1000mL/瓶 | 用于念珠菌特别是白色念珠菌的选择性分离和初步鉴别 |
| CRM010P1 | 念珠菌显色培养基平板 | 90mm×20个/盒 | |
| CRM016 | 念珠菌显色培养基(20版药典) | 1000mL/瓶 | |
| CRM011 | 志贺氏菌显色培养基 | 1000mL/瓶 | 用于志贺氏菌的选择性分离和初步鉴别 |
| CRM011A | 志贺氏菌显色培养基平板 | 90mm×20个/盒 | |
| CRM012 | 金黄色-葡萄球菌显色培养基 | 1000mL/瓶 | 用于金黄色-葡萄球菌的分离和初步鉴别 |
| CRM012A | 金黄色-葡萄球菌显色培养基平板 | 90mm×20个/盒 | |
| CRM013 | 单增李斯特氏菌显色培养基 | 1000mL/瓶 | 用于分离和初步鉴别单增李斯特氏菌 |
| CRM013P1 | 单增李斯特氏菌显色培养基平板 | 90mm×20个/盒 | |
| CRM017 | 克罗诺杆菌显色培养基 | 1000mL/瓶 | 主要用于婴儿奶粉以及其他食品中的克罗诺杆菌属(阪崎肠杆菌)的初步鉴别和计数 |
风险提示:丁香通仅作为第三方平台,为商家信息发布提供平台空间。用户咨询产品时请注意保护个人信息及财产安全,合理判断,谨慎选购商品,商家和用户对交易行为负责。对于医疗器械类产品,请先查证核实企业经营资质和医疗器械产品注册证情况。
文献和实验美国佛罗里达中央大学的微生物学教授Keith Ireton的科研小组发现了致死性食源性细菌一个先前未被了解的的传播机制。 李斯特氏菌(Listeria monocytogenes)是一种细菌。它会导致怀孕妇女流产,在老年人和免疫系统损伤人群中引起脑膜炎。2002年在美国多个州就爆发了利斯特氏菌病。
作者:张淑红,吴清平,张菊梅 作者单位:广东环凯微生物科技有限公司,广州510070;2.广东省微生物研究所广东省菌种保藏与应用重点实验室,广州510070 [摘要] 目的:研究显色培养基对单核细胞增生李斯特菌的检测效果,探讨建立新型快速检测方法。方法:检测按国标GB4789—33程序进行。结果:人工污染样品和实际样品检测中,显色培养基CHROMagar Listeria和HKListeria与传统平板OXA和MMA可以达到相同的检测限和灵敏度,且具有更高
于100mL亚硒酸盐肮氨酸(SC)增菌液内,于36±1℃培养18~24h。5.2 分离取增菌液1环,划线接种于一个亚硫酸铋琼脂平板和一个DHL琼脂平板。两种增菌液可同时划线接种在同一个平板上。于36±1℃分别培养18~24h(DHL)或40~48h(BS),观察各个平板上生长的菌落,沙门氏菌Ⅰ、Ⅱ、Ⅳ、Ⅴ、Ⅵ和沙门氏菌Ⅲ在各个平板上的菌落特征见表1。表1 沙门氏菌属各群在各种选择性琼脂平板上的菌落特征5.3 生化试验 5.3.1 自选择性琼脂平板上直接挑取数个可疑菌落,分别接种三糖铁琼脂。在三糖
技术资料










